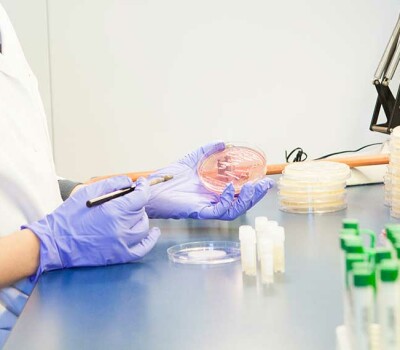
mg8373

Antimicrobial Resistance
Background
Antimicrobial resistance (AMR) arises when bacteria, viruses, fungi, and parasites evolve over time and no longer respond to treatment. Globalisation, migration, and (medical) tourism inevitably contribute to the worldwide spread of new (multi-)resistant mutant pathogens.
Our research
AMR is a crisis that intersects with many of the health challenges we address, from (myco)bacterial infections and leishmaniasis to HIV. The ecological, sanitary, and socioeconomic conditions that drive the overuse and misuse of antibiotics have never disappeared. In fact, due to urbanisation, population growth, and migration, the situation has worsened in many areas.
It is urgent to change how patients are diagnosed and how antibiotics are prescribed, distributed, and used. Additionally, the role of animal healthcare and infection prevention and control in healthcare facilities cannot be overlooked. Adequate diagnostic and treatment facilities are scarce, and to make matters worse, antibiotics of uncontrolled, often inadequate quality are widely available to uninformed populations and unlicensed or unskilled healthcare providers. Untreatable infections are becoming alarmingly frequent, while the research and development pipeline in the pharmaceutical industry remains extremely thin.
At ITM, we are coordinating research projects to combat AMR. An interdisciplinary approach is essential to counter this persistent threat. Our scientists collaborate on the development of novel diagnostic tools and treatment strategies for infection prevention and control, promote responsible antibiotic use, and investigate human, social, and cultural factors.
Last updated: 18 December 2025
Success stories

Better adapted diagnostics for bloodstream infections in sub-Saharan Africa
Our SIMBLE project focused on developing a field-adapted blood culture bottle reading system and establishing a local manufacturing plant for bacteriological culture media (BactInsight) in Cotonou, Benin. It was unique in its aspects of reverse innovation, led by scientists from resource-limited settings, and in its ability to generate interest in local production and in vitro diagnostics. The project was funded by EDCTP.

Leishmaniasis and drug tolerance
The deadly Leishmania parasite is notorious for adapting to drugs through mutations and drug resistance. Our molecular parasitologists have discovered a second way it evades drug attacks: drug tolerance. This can lead to serious complications. Their findings were published in the esteemed journal Frontiers in Cellular and Infection Microbiology.

Rwandan PhD student unveils problem of multi-drug resistant tuberculosis and false resistance
Drug resistance is increasing in tuberculosis (TB), the world's deadliest infectious disease. Timely detection of resistance is essential to select the most appropriate treatment. Claude Semuto, a Rwandan PhD student, exposed a serious problem of false rifampicin resistance. His findings, published in Lancet Microbe, changed the diagnostic algorithm of the National TB Programme and enabled patients to receive proper care.

Monitoring the emergence of drug resistance in leprosy in the Comoros
We conducted a countrywide drug resistance survey in the Comoros and investigated whether post-exposure prophylaxis (PEP) with rifampicin led to the emergence of drug resistance in patients with leprosy. The results demonstrated that Mycobacterium leprae remains fully susceptible to rifampicin, fluoroquinolones, and dapsone. For the first time, our researchers showed the applicability of targeted sequencing directly on skin biopsies from patients with either paucibacillary or multibacillary leprosy. The findings were published in Lancet Microbe.

Rising resistance in sexually transmitted infections
There is a growing need for alternatives to antibiotics to prevent the transmission of STIs such as gonorrhoea, chlamydia, and syphilis. In the PReGo study, we aimed to test novel strategies to prevent the emergence of AMR in Neisseria gonorrhoeae. Our findings showed that Listerine and chlorhexidine mouthwashes cannot treat or prevent pharyngeal gonorrhoea. The study was funded by FWO, and the results were published in The Lancet Infectious Diseases and Sexually Transmitted Diseases.

N. gonorrhoea and C. trachomatis screening does more harm than good
We conducted a randomised controlled trial across five screening centres in Belgium and found that screening for N. gonorrhoeae and C. trachomatis in men who have sex with men (MSM) using HIV pre-exposure prophylaxis (PrEP) does more harm than good. The results of this study, published in Lancet HIV, led to changes in the Belgian HIV PrEP guidelines regarding the screening approach for these infections.